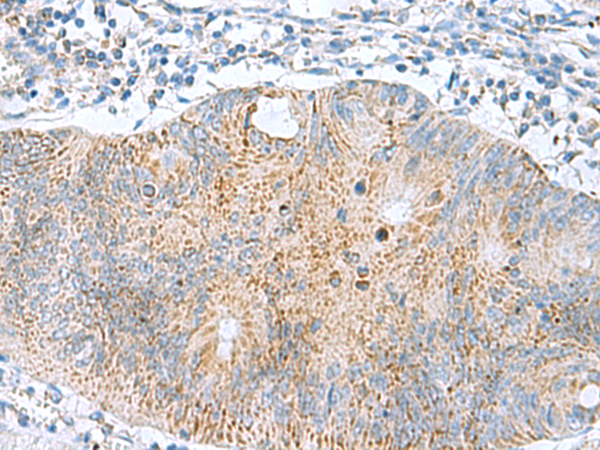

中文名稱(chēng): 兔抗GCSH多克隆抗體
宿 主: Rabbit
|
Background: |
Degradation of glycine is brought about by the glycine cleavage system, which is composed of four mitochondrial protein components: P protein (a pyridoxal phosphate-dependent glycine decarboxylase), H protein (a lipoic acid-containing protein), T protein (a tetrahydrofolate-requiring enzyme), and L protein (a lipoamide dehydrogenase). The protein encoded by this gene is the H protein, which transfers the methylamine group of glycine from the P protein to the T protein. Defects in this gene are a cause of nonketotic hyperglycinemia (NKH). Two transcript variants, one protein-coding and the other probably not protein-coding,have been found for this gene. Also, several transcribed and non-transcribed pseudogenes of this gene exist throughout the genome. |
|
Applications: |
ELISA, IHC |
|
Name of antibody: |
GCSH |
|
Immunogen: |
Fusion protein of human GCSH |
|
Full name: |
glycine cleavage system protein H |
|
Synonyms: |
GCE; NKH |
|
SwissProt: |
P23434 |
|
ELISA Recommended dilution: |
5000-10000 |
|
IHC positive control: |
Human liver cancer and Human colorectal cancer |
|
IHC Recommend dilution: |
50-200 |

購(gòu)物車(chē)
購(gòu)物車(chē) 幫助
幫助
 021-54845833/15800441009
021-54845833/15800441009
